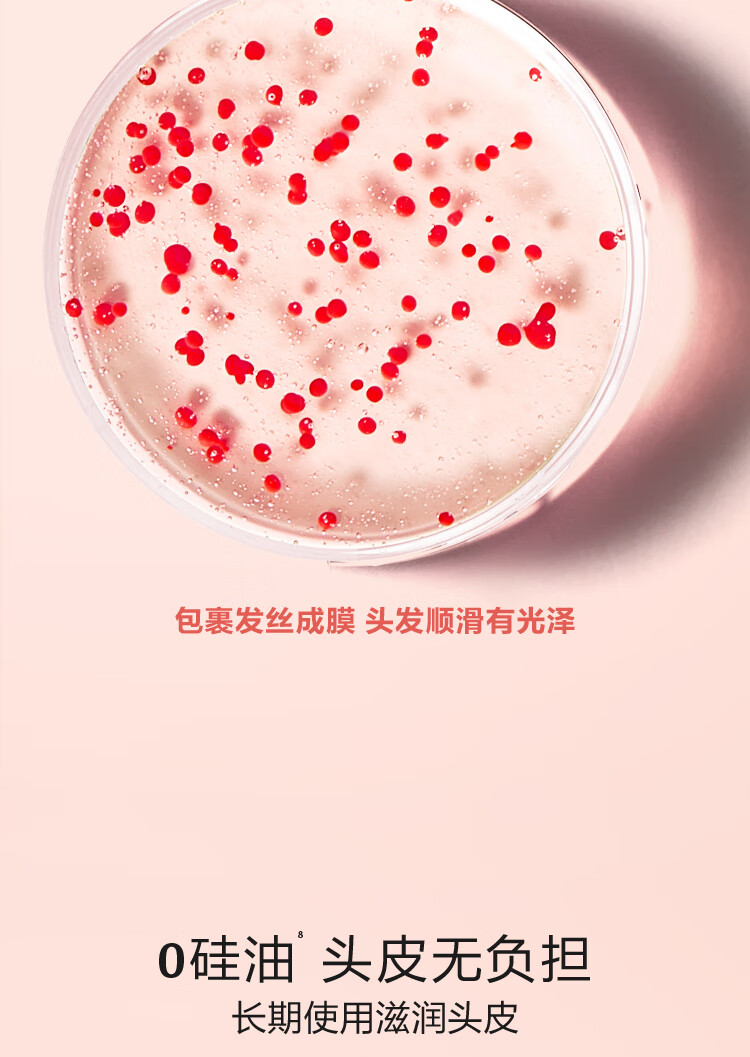

馥绿德雅强韧丰盈洗发露600ml/117985 丰盈蓬松改善细软塌
¥258.00
限时折扣
原价:¥308.00
| 运费: | ¥ 6.00-12.00 |
| 库存: | 20 件 |
商品详情

- 常青藤食品
- 扫描二维码,访问我们的微信店铺